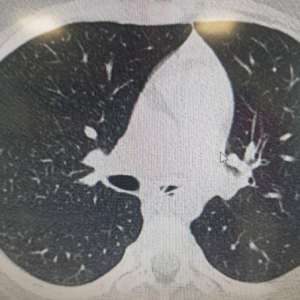
Image

2 годы назад
2 годы назад
Анонимно пожалуйста! предложили должность инспектора иаз, в гаи. подскажите чем они занимаются, тяжелая работа? какая зп
2 годы назад
Всех приветствую. Хочу устроиться в полицию, но имеется 2 тату, крест на груди и надпись "Спаси и Сохрани" на спине. Я читал, что с религиозными тату нельзя. Нужно их будет сводить, или брехню в интернете пишут?
2 годы назад
Опубликованы зарплаты главных бухгалтеров и начальников ФКУ и ФКУЗ. Есть к чему стремиться. Полный список во вложении
2 годы назад
Анончик
Ребята не кого случаем с Липецка нет? И области?
Хотелось бы узнать как обстоят дела с ВВК? И можно ли вообще на службу попасть, просто у меня хватает болезней хронических, и то что поступлю шансов не много. Но может они щас закрывают глаза на болезни,тогда и у меня шанс есть,а то ведь сейчас не хватка.
В идеале хотел бы попасть в дпс, но говорят там 1 группа предназначения, так что видать это только мечта, а я потяну дай бог на 3-4,так что вакансии видать один шлак мне достанется, а на такой вариант подписываться желания нет.
Так что хочеться узнать что щас с ВВК в городе,чтоб не тратить свое время.
Ребята не кого случаем с Липецка нет? И области?
Хотелось бы узнать как обстоят дела с ВВК? И можно ли вообще на службу попасть, просто у меня хватает болезней хронических, и то что поступлю шансов не много. Но может они щас закрывают глаза на болезни,тогда и у меня шанс есть,а то ведь сейчас не хватка.
В идеале хотел бы попасть в дпс, но говорят там 1 группа предназначения, так что видать это только мечта, а я потяну дай бог на 3-4,так что вакансии видать один шлак мне достанется, а на такой вариант подписываться желания нет.
Так что хочеться узнать что щас с ВВК в городе,чтоб не тратить свое время.
Показать больше
2 годы назад
Оперативый блокнот(1).
Или день из жизни Кузьмоловского отделения милиции.
В начале лихих 90х началась размеренная будничная жизнь у граждан, свободные нравы, западные интересы и прочие прелести той эпохи.
Шло очередное суточное дежурство, в принципе как шло? Оно уже подходило к концу, ночь была спокойной, на огонек в окне кабинета заглянул знакомый, опоздавший на последнюю электричку и вынужденный коротать время до открытия метро, так как жил на другом конце города.
Сидели пили чай, кофе обсуждая и мечтая о будущей жизни в условиях надвигающегося капитализма. Ночь прошла быстро. До открытия метро Комсомольская оставалось не так и много. А так как все было спокойно, то и решил подкинуть знакомого до Мурино.
К 5 утра, к открытию отвез к метро, расстались, и поехал готовить доклад о прошедших сутках и в предверии отсыпного уйти домой.
Возвращаясь в отделение по безлюдному шоссе в районе Северной ТЭЦ увидев на обочине белую шестерку и какую то суету слегка сбавил скорость, приблизившись пришлось лицезреть будничную для того времени картину. Трое в черных по тем временам модных,костюмах, белых рубашках шмаляли из пистолета по кустам с обочины(малиновые пиджаки вошли в моду чуть позже). Блокировав их шестерку своей любимой копеечкой, выскочив из авто и передернув затвор служебного ПМа, предложил присутствующим господам не палить по «воробьям», и объяснить суть происходящего ранним утром на безлюдной дороге.
Но господам видимо не понравилась тональность претензии и манера изложения, хотя и служебное удостоверение было предемонстрировано единомоментно с ПМом как аргумент для серьезности разговора. Трое буром поперли живым щитом на сближение, пытаясь объяснить свою причастность к системе МВД(со слов), и свои благие намерения в разговоре. Пожарные тогда еще не входили в позже созданное МЧС и так же разделяли участь службы в МВД. Но как то боевой настрой их не настроил на проведение мирных переговоров в столь раний час на безлюдной дороге. И пришлось ласково и убедительно повторить свою просьбу о том чтоб свою пулялку отбросили в мою сторону, а сами аккуратно, чтоб не испачкав свой прикид все же прилегли лицами к асфальту сложив правую и левую руки над головой, для продолжения диалога.
Видимо чуйка все же сыграла в их головах, что данный конфликт может приобрести более тяжелые последствия и как не странно эти трое исполнили пожелания, разместившись на обочине дороги, отшвырнув в мою сторону, то, что несколькими минутами ранее издавало довольно таки громкие хлопки очень похожие на выстрелы.
Тут уже как истиный джентельмен, подобрав пистолет и определив, что это всего то газовый «Вальтер РР» и в принципе не представляющий потенциальной угрозы, продолжили разговор о том, что воробьи тоже хотят жить, что природу в столь ранний час надо беречь, да и вообще к чему все это подобное, поинтересовался, а есть ли разрешение на данный предмет, столь шумно издающий звуки. Один из отдыхавших, лежавших на обочине сказал, что с собой нет разрешения, а вообще они законопослушные, и все у них хорошо с этим.
Ну на нет, и суда нет. Закинув Вальтер к себе в авто, сказал где меня можно найти и когда у меня часы приема для подобных «знакомств», пожелав всем присутствующим всего хорошего, и до новых встреч поехал сдавать дежурство. Наблюдая как эти трое поднявшись отряхивали от дорожной пыли свои манерные костюмы что то бурно обсуждали.
Вернувшись в отделение, погрузившись в рутину бумажной работы продолжил подготовку к выходному, отложив в сторону «трофей» до приезда, как оказалось коллег из смежной службы МВД. Да и коллеги не заставили долго ждать своего присутствия, видимо беседа была столь убедительная, а речь настолько запоминающаяся, что и адрес и номер кабинета были ими хорошо записаны с первого раза на корочку головного мозга.
Тук-тук, раздался звук, а можно? Спросил молодой с виду порядочный как оказалось тоже пожарный, да и еще державший в дрожащих руках столь заветный и желаемый для обозрения документ – разрешение на тот самый «Вальтер РР». Кстати, как оказалось владелец Вальтера был не в числе тех троих, любителей нарушить утреннюю тишину.
Сверив номера на «Вальтере РР» и тем самым документом, который столь скоротечно был привезен в отделение, буквально за несколько часов, пока даже с дежурства не успел уйти, пришлось с трофеем расстаться, пожелав его владельцу не допускать подобного и жить мирно и счастливо. После чего гость удалился со своей игрушкой. На этом можно было бы и закончить то повествование. НО !
Через день в отделение, возможно и в гости, но скорей по иным причинам пришла хорошо слаженная блондинка в огромных солнцезащитных очках, хотя на улице и солнца не было. И знакомство наше началось с повествования грустной истории произошедшей с ней как раз таки за день, точней ночь, описываемую мной ранее.
А дело было так, приехала эта дама в гости к своему знакомому финну в гости в отель «Москва», что на пл.Александра Невского в Ленинграде. Уже вечером, выйдя к автобусной остановке напротив отеля, применив физическое насилие трое затолкали ее в авто белого цвета, без желания и согласия на поездку и прогулку по вечернему городу. Где применив физическую силу и угрозы, включая и демонстрацию пистолета заставили употребить спиртное. Наименование водки она не запомнила, но говорит, что пить не желала, и только силой в нее влили большое количество. К тому же в подтверждение к сказаному она слегка приподняла солнцезащитные очки. Свидетельства той встречи были явно на лице. Кроме того с ее слов встреча и поездки по ночному городу и не только вопреки ее желанию затянулись да еще и сопровождались периодически не столь приятными групповичками и фактами насилия и издевательств. О чем так же свидетельствовали синяки на теле, ссадины и ушибы. Окончание той встречи было не столь шикарным со слов потерпевшей. Очнулась она полностью голая, раздетая в придорожной канаве недалеко от кольца автобуса 562, что было напротив завода «ТурбоатомГаз» (ныне газозаправочная станция). И подойдя к водителю попросила оказать помощь и отвезти к метро или до дома. Кондуктор отдала ей свой рабочий халат. Так, в одном халате, и босиком до дома и добралась. А описание ее «новых» знакомых явно совпадало с теми тремя стрелками по воробьям на дороге. Заявление было принято, процессуальные формальности соблюдены.
Из воспоминаний о той утренней встрече в голом остатке на память приходило только, что газовый «Вальтер РР». Регистрация в разрешительной службе в одном из городских районов, и что «коллеги» пожарные из МВД.
Ну что, напарник, поехали? Напраник почуяв интересный маневр в оперативной работе и то, что будет весьма интересно узнав все известные обстоятельства согласился поучаствовать. Оседлав копеечку поехали в районную разрешиловку города. Коллеги из разрешительной службы узнав об обстоятельствах пошли на встречу и не стали ограничивать доступ к картотеке зарегистрированного оружия. А картотека в те времена предстваляла большой шкаф с картонными карточками ровными рядами стоящими на полочках. До компьютеров в МВД и их внедрения оставалось еще несколько лет. И вот оно, и «Вальтер РР» и под описание с фото владельца полностью подпадает тот гость забравший столь быстро свою игрушку у меня.
Да и легкий фарт, в том что и живет то рядом с разрешительной. Чтож в гости то не зайти сразу? Вот заветный подьезд сталинки, лифта нет, пролеты лестниц большие. Мы с напарником наверх, а нам на встречу сам цокая по ступенькам идет теперь уже знакомый пожарный.
Привет ! Не доброго дня! Он слегка обомлел от столь оперативной встречи после расставания. Ну и после скоротечной беседы, все начало вставать на свои места. Газовички по тем временам были в дефиците, не каждый мог себе купить такой за доллары. А у них как оказалось «халтура» была после службы в пожарке. Не много ни мало, а охранять валютный обменник в Гранд-отеле «ЕВРОПА», том что в центре города на Невском. Грабежи обменников в те времена были столь частыми, как посиделки с домино во дворах, с криками «рыба». Подстраховались пожарные для халтуры таким образом. Да и друзья товарищи из тех, что как раз таки стреляли по воробьям на смене. А пистолетик был приобретен один на всех, так сказать всем колхозом копили. Вот же везение, все
и сразу и на своих местах. Благо тогда еще не было мобилок и информация не улетала быстрей шмеля. Да и с пробками на дорогах было попроще. Домчались на копеечке молниеносно, припарковав у парадного входа. И счастье не заставило себя ждать. Стоят родимые, двое, как положено в манерных черных, да и с белыми рубашками и в галстучках в фойе у обменника. На этот раз уже без каких либо убеждений пистолетик был изьят, а на запястья защелкнули не модные, но надежные браслеты. И поехали в отдел для опознания и дальнейших мероприятий.
Двое в наличии, не столь много времени заняло и установление их третьего пассажира, проживавшего в доме, если кто помнит где ресторан «Невские Берега» на Октябрьской набережной. Тода только начали входить в моду железные двери. Поднявшись на этаж, поняв, что владелец из тех самых модных, не стали ломать, долбить и хулиганить(про дверь), а просто подождали минут 20-30 пока «Сережа выйдет». «Тяжелых» тогда на подобные мероприятия и не привлекали, как теперь принято показывать по телевизору. Тем более, что у подьезда его ожидали друзья, к тому же подсказавшие нам как раз таки и квартиру, так как изначально знали только подьезд.
Так и собрали в кучку всех трех «ночных мачо», передав дело в течении суток по подследственности в Прокуратуру. Раньше это называлось «По горячим следам».
Или день из жизни Кузьмоловского отделения милиции.
В начале лихих 90х началась размеренная будничная жизнь у граждан, свободные нравы, западные интересы и прочие прелести той эпохи.
Шло очередное суточное дежурство, в принципе как шло? Оно уже подходило к концу, ночь была спокойной, на огонек в окне кабинета заглянул знакомый, опоздавший на последнюю электричку и вынужденный коротать время до открытия метро, так как жил на другом конце города.
Сидели пили чай, кофе обсуждая и мечтая о будущей жизни в условиях надвигающегося капитализма. Ночь прошла быстро. До открытия метро Комсомольская оставалось не так и много. А так как все было спокойно, то и решил подкинуть знакомого до Мурино.
К 5 утра, к открытию отвез к метро, расстались, и поехал готовить доклад о прошедших сутках и в предверии отсыпного уйти домой.
Возвращаясь в отделение по безлюдному шоссе в районе Северной ТЭЦ увидев на обочине белую шестерку и какую то суету слегка сбавил скорость, приблизившись пришлось лицезреть будничную для того времени картину. Трое в черных по тем временам модных,костюмах, белых рубашках шмаляли из пистолета по кустам с обочины(малиновые пиджаки вошли в моду чуть позже). Блокировав их шестерку своей любимой копеечкой, выскочив из авто и передернув затвор служебного ПМа, предложил присутствующим господам не палить по «воробьям», и объяснить суть происходящего ранним утром на безлюдной дороге.
Но господам видимо не понравилась тональность претензии и манера изложения, хотя и служебное удостоверение было предемонстрировано единомоментно с ПМом как аргумент для серьезности разговора. Трое буром поперли живым щитом на сближение, пытаясь объяснить свою причастность к системе МВД(со слов), и свои благие намерения в разговоре. Пожарные тогда еще не входили в позже созданное МЧС и так же разделяли участь службы в МВД. Но как то боевой настрой их не настроил на проведение мирных переговоров в столь раний час на безлюдной дороге. И пришлось ласково и убедительно повторить свою просьбу о том чтоб свою пулялку отбросили в мою сторону, а сами аккуратно, чтоб не испачкав свой прикид все же прилегли лицами к асфальту сложив правую и левую руки над головой, для продолжения диалога.
Видимо чуйка все же сыграла в их головах, что данный конфликт может приобрести более тяжелые последствия и как не странно эти трое исполнили пожелания, разместившись на обочине дороги, отшвырнув в мою сторону, то, что несколькими минутами ранее издавало довольно таки громкие хлопки очень похожие на выстрелы.
Тут уже как истиный джентельмен, подобрав пистолет и определив, что это всего то газовый «Вальтер РР» и в принципе не представляющий потенциальной угрозы, продолжили разговор о том, что воробьи тоже хотят жить, что природу в столь ранний час надо беречь, да и вообще к чему все это подобное, поинтересовался, а есть ли разрешение на данный предмет, столь шумно издающий звуки. Один из отдыхавших, лежавших на обочине сказал, что с собой нет разрешения, а вообще они законопослушные, и все у них хорошо с этим.
Ну на нет, и суда нет. Закинув Вальтер к себе в авто, сказал где меня можно найти и когда у меня часы приема для подобных «знакомств», пожелав всем присутствующим всего хорошего, и до новых встреч поехал сдавать дежурство. Наблюдая как эти трое поднявшись отряхивали от дорожной пыли свои манерные костюмы что то бурно обсуждали.
Вернувшись в отделение, погрузившись в рутину бумажной работы продолжил подготовку к выходному, отложив в сторону «трофей» до приезда, как оказалось коллег из смежной службы МВД. Да и коллеги не заставили долго ждать своего присутствия, видимо беседа была столь убедительная, а речь настолько запоминающаяся, что и адрес и номер кабинета были ими хорошо записаны с первого раза на корочку головного мозга.
Тук-тук, раздался звук, а можно? Спросил молодой с виду порядочный как оказалось тоже пожарный, да и еще державший в дрожащих руках столь заветный и желаемый для обозрения документ – разрешение на тот самый «Вальтер РР». Кстати, как оказалось владелец Вальтера был не в числе тех троих, любителей нарушить утреннюю тишину.
Сверив номера на «Вальтере РР» и тем самым документом, который столь скоротечно был привезен в отделение, буквально за несколько часов, пока даже с дежурства не успел уйти, пришлось с трофеем расстаться, пожелав его владельцу не допускать подобного и жить мирно и счастливо. После чего гость удалился со своей игрушкой. На этом можно было бы и закончить то повествование. НО !
Через день в отделение, возможно и в гости, но скорей по иным причинам пришла хорошо слаженная блондинка в огромных солнцезащитных очках, хотя на улице и солнца не было. И знакомство наше началось с повествования грустной истории произошедшей с ней как раз таки за день, точней ночь, описываемую мной ранее.
А дело было так, приехала эта дама в гости к своему знакомому финну в гости в отель «Москва», что на пл.Александра Невского в Ленинграде. Уже вечером, выйдя к автобусной остановке напротив отеля, применив физическое насилие трое затолкали ее в авто белого цвета, без желания и согласия на поездку и прогулку по вечернему городу. Где применив физическую силу и угрозы, включая и демонстрацию пистолета заставили употребить спиртное. Наименование водки она не запомнила, но говорит, что пить не желала, и только силой в нее влили большое количество. К тому же в подтверждение к сказаному она слегка приподняла солнцезащитные очки. Свидетельства той встречи были явно на лице. Кроме того с ее слов встреча и поездки по ночному городу и не только вопреки ее желанию затянулись да еще и сопровождались периодически не столь приятными групповичками и фактами насилия и издевательств. О чем так же свидетельствовали синяки на теле, ссадины и ушибы. Окончание той встречи было не столь шикарным со слов потерпевшей. Очнулась она полностью голая, раздетая в придорожной канаве недалеко от кольца автобуса 562, что было напротив завода «ТурбоатомГаз» (ныне газозаправочная станция). И подойдя к водителю попросила оказать помощь и отвезти к метро или до дома. Кондуктор отдала ей свой рабочий халат. Так, в одном халате, и босиком до дома и добралась. А описание ее «новых» знакомых явно совпадало с теми тремя стрелками по воробьям на дороге. Заявление было принято, процессуальные формальности соблюдены.
Из воспоминаний о той утренней встрече в голом остатке на память приходило только, что газовый «Вальтер РР». Регистрация в разрешительной службе в одном из городских районов, и что «коллеги» пожарные из МВД.
Ну что, напарник, поехали? Напраник почуяв интересный маневр в оперативной работе и то, что будет весьма интересно узнав все известные обстоятельства согласился поучаствовать. Оседлав копеечку поехали в районную разрешиловку города. Коллеги из разрешительной службы узнав об обстоятельствах пошли на встречу и не стали ограничивать доступ к картотеке зарегистрированного оружия. А картотека в те времена предстваляла большой шкаф с картонными карточками ровными рядами стоящими на полочках. До компьютеров в МВД и их внедрения оставалось еще несколько лет. И вот оно, и «Вальтер РР» и под описание с фото владельца полностью подпадает тот гость забравший столь быстро свою игрушку у меня.
Да и легкий фарт, в том что и живет то рядом с разрешительной. Чтож в гости то не зайти сразу? Вот заветный подьезд сталинки, лифта нет, пролеты лестниц большие. Мы с напарником наверх, а нам на встречу сам цокая по ступенькам идет теперь уже знакомый пожарный.
Привет ! Не доброго дня! Он слегка обомлел от столь оперативной встречи после расставания. Ну и после скоротечной беседы, все начало вставать на свои места. Газовички по тем временам были в дефиците, не каждый мог себе купить такой за доллары. А у них как оказалось «халтура» была после службы в пожарке. Не много ни мало, а охранять валютный обменник в Гранд-отеле «ЕВРОПА», том что в центре города на Невском. Грабежи обменников в те времена были столь частыми, как посиделки с домино во дворах, с криками «рыба». Подстраховались пожарные для халтуры таким образом. Да и друзья товарищи из тех, что как раз таки стреляли по воробьям на смене. А пистолетик был приобретен один на всех, так сказать всем колхозом копили. Вот же везение, все
и сразу и на своих местах. Благо тогда еще не было мобилок и информация не улетала быстрей шмеля. Да и с пробками на дорогах было попроще. Домчались на копеечке молниеносно, припарковав у парадного входа. И счастье не заставило себя ждать. Стоят родимые, двое, как положено в манерных черных, да и с белыми рубашками и в галстучках в фойе у обменника. На этот раз уже без каких либо убеждений пистолетик был изьят, а на запястья защелкнули не модные, но надежные браслеты. И поехали в отдел для опознания и дальнейших мероприятий.
Двое в наличии, не столь много времени заняло и установление их третьего пассажира, проживавшего в доме, если кто помнит где ресторан «Невские Берега» на Октябрьской набережной. Тода только начали входить в моду железные двери. Поднявшись на этаж, поняв, что владелец из тех самых модных, не стали ломать, долбить и хулиганить(про дверь), а просто подождали минут 20-30 пока «Сережа выйдет». «Тяжелых» тогда на подобные мероприятия и не привлекали, как теперь принято показывать по телевизору. Тем более, что у подьезда его ожидали друзья, к тому же подсказавшие нам как раз таки и квартиру, так как изначально знали только подьезд.
Так и собрали в кучку всех трех «ночных мачо», передав дело в течении суток по подследственности в Прокуратуру. Раньше это называлось «По горячим следам».
Показать больше
2 годы назад
В Молдове 28-летний мужчина, ранее судимый за грабеж и убийство, избил женщину, которую пытался изнасиловать. На минувшей неделе его задержали в Кишиневе, после чего отправили под арест на 72 часа.
Однако прокуроры освободили его, поскольку "он понял свою ошибку и решил изменить свою жизнь и поведение".
Он отправился к женщине, которая пожаловалась в полицию на избиение. Женщину он снова избил, а затем нанес ей ножом около 20 ударов, после чего перерезал ей горло.
Однако прокуроры освободили его, поскольку "он понял свою ошибку и решил изменить свою жизнь и поведение".
Он отправился к женщине, которая пожаловалась в полицию на избиение. Женщину он снова избил, а затем нанес ей ножом около 20 ударов, после чего перерезал ей горло.
Показать больше
2 годы назад
Во Львове 6-летняя Яна еще в марте начала жаловаться на тяжелое дыхание и сильный кашель, поэтому родители девочки обратились в больницу. Там ребенку поставили диагноз – обструктивный бронхит. Однако, несмотря на тщательное лечение, состояние девочки не улучшалось, поэтому Яну направили на дообследование в «Охматдет».
При обследовании в детской больнице медики обнаружили в дыхательных путях Яны постороннее тело. Выяснилось, что это была пластиковая ложка 4 см длиной.
«Нетипичным было размещение ложечки в левом бронхе. Ведь почти всегда посторонние предметы попадают в правую сторону. Также удивило то, что девочке 6 лет. Обычно подобные случаи происходят с детьми младше 3 лет», — рассказал заведующий педиатрическим отделением «Охматдета» Сергей Руденко.
При обследовании в детской больнице медики обнаружили в дыхательных путях Яны постороннее тело. Выяснилось, что это была пластиковая ложка 4 см длиной.
«Нетипичным было размещение ложечки в левом бронхе. Ведь почти всегда посторонние предметы попадают в правую сторону. Также удивило то, что девочке 6 лет. Обычно подобные случаи происходят с детьми младше 3 лет», — рассказал заведующий педиатрическим отделением «Охматдета» Сергей Руденко.
Показать больше
2 годы назад
В Каменске-Уральском в клубе убили известного местного спортсмена
В ночь на субботу в клубе Джой на Красногорская, 50А был убит тремя выстрелами в голову из, предположительно пневматического пистолета, известный в городе боксер Александр Максимов. Саша работал телохранителем.
Полиция разыскивала причастных к инциденту Бабушкина Олега, 1986 года рождения и Мальцева Сергея, 1990 года рождения. Их оперативно удалось задержать.
По словам очевидцев, инцидент произошел из-за конфликта. Что не поделили посетители - выясняют следователи.
В ночь на субботу в клубе Джой на Красногорская, 50А был убит тремя выстрелами в голову из, предположительно пневматического пистолета, известный в городе боксер Александр Максимов. Саша работал телохранителем.
Полиция разыскивала причастных к инциденту Бабушкина Олега, 1986 года рождения и Мальцева Сергея, 1990 года рождения. Их оперативно удалось задержать.
По словам очевидцев, инцидент произошел из-за конфликта. Что не поделили посетители - выясняют следователи.
Показать больше
2 годы назад
В Башкирии скончалась юная участница спортивных забегов
19-летняя Виктория из Белорецка принимала участие в программе марафона "Малидак", проходившего с 11 августа по сегодняшний день в Башкирии. Марафон включает в себя разные дисциплины: от 5 км до ультрамарафонской дистанции по башкирским горам в 100 км. Вика принимала участие в забеге, суть которого заключалась в следующем: бежишь 400 метров, выпиваешь кумыс, снова бежишь, и так четыре раза.
Во время этого забега Вике стало плохо. Реанимационные мероприятия не увенчались успехом, и юная спортсменка скончалась. По предварительным данным, девушка скрыла от организаторов тот факт, что болеет астмой. По одной из версий, у нее случился приступ во время соревнований. Другая версия гласит о том, что Вике стало плохо с сердцем. Так или иначе, окончательную причину смерти должны установить судмедэксперты.
19-летняя Виктория из Белорецка принимала участие в программе марафона "Малидак", проходившего с 11 августа по сегодняшний день в Башкирии. Марафон включает в себя разные дисциплины: от 5 км до ультрамарафонской дистанции по башкирским горам в 100 км. Вика принимала участие в забеге, суть которого заключалась в следующем: бежишь 400 метров, выпиваешь кумыс, снова бежишь, и так четыре раза.
Во время этого забега Вике стало плохо. Реанимационные мероприятия не увенчались успехом, и юная спортсменка скончалась. По предварительным данным, девушка скрыла от организаторов тот факт, что болеет астмой. По одной из версий, у нее случился приступ во время соревнований. Другая версия гласит о том, что Вике стало плохо с сердцем. Так или иначе, окончательную причину смерти должны установить судмедэксперты.
Показать больше
При финансовой поддержке
Memes Admin
4 мс. назад